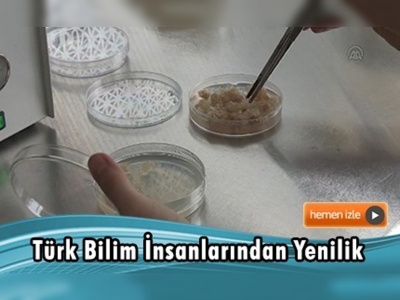
Transgenik teknolojiyle güveye dirençli domates çeşidi geliştirildi

Domates rekoltesine yüzde 100'e varan oranlarda zarar veren güveye karşı çalışma yürüten Türk bilim insanları, transgenik teknolojiyle güveye dirençli domates çeşidi geliştirdi.
İzmit Yüksek Teknoloji Enstitüsünde (İYTE) yürütülen bilimsel çalışmalarda güveye karşı dayanıklılık verecek toksin geni domates genine transgenik teknolojiyle aktarıldı.
İYTE Moleküler Biyoloji Öğretim Üyesi Prof. Dr. Sami Doğanlar, domates başta olmak üzere tüm tarla ürünlerindeki dayanıklılık genlerinin 40-50 yıllık yaşlı genler olduğunu belirtti. Doğanlar, zamanla hastalığa neden olan organizmaların yeni ırklarının çıktığını, ürünlerin dayanıklılığını da yavaş yavaş kaybettiğini söyledi. Mevcut genlerle gelecek yıllarda ürün alma ihtimalinin bulunmadığını savunan Doğanlar, bu nedenle yeni dayanıklılık genlerinin bulunmasının büyük önem taşıdığını ifade etti.
Doktora öğrencisi Hatice Şelale de bitki dokusundan beslenen güvenin mücadelesinde 2 ila 3 hafta aralığında ilaçlama gerektiğini anlattı. Kullanılan kimyasal ve pestisitlerin etkisiz olduğuna dikkat çeken Şelale, geliştirilen yöntemin kimyasal ilaçlamayıminimize edeceğini savundu.

Siirt’te buğday hasadı şenlikle başladı. Kentte buğday üretiminin...
Devamını Oku ->
Çankırı İl Tarım ve Orman Müdürlüğü, “Kırsal Dezavantajlı Alanlar...
Devamını Oku ->
Kastamonu'da lise öğrencileri, atık ve doğadan topladıkları...
Devamını Oku ->
Samsun İl Tarım ve Orman Müdürlüğü’nün, “Altındaneler Toprakla...
Devamını Oku ->
Mardin'de orman yangınlarıyla mücadele ve ormancılık...
Devamını Oku ->
"Kırsal Kalkınmada Uzman Eller Projesi"nin hibe desteğinden...
Devamını Oku ->
İzmir’in Seferihisar ilçesinde üretilen yavru sazan balıkları, iç...
Devamını Oku ->
İzmir Kınık Organize Tarım Bölgesi'nde oluşturulacak yüksek...
Devamını Oku ->